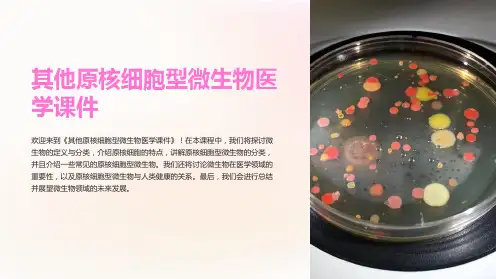

原核细胞型微生物
- 格式:ppt
- 大小:1.75 MB
- 文档页数:55



微生物学练习题——多项选择题1.原核细胞型微生物是指A.细菌B.放线菌C.支原体D.衣原体E.螺旋体2.真核细胞型微生物是指A.新型隐球菌B.白色念珠菌C.真菌D.放线菌E.立克次体3.革兰阳性菌细胞壁的主要化学组成为A.脂蛋白B.肽聚糖C.脂多糖D.磷壁酸E.核心多糖4.荚膜的功能是A抗吞噬作用 B.抗干燥作用 C.抗有害物质的损伤作用D.与细菌鉴别有关E.与某些细菌的分型有关5.IMViC试验主要用于区别下列哪两种病原菌A.产气杆菌B.破伤风梭菌C.葡萄球菌D.大肠杆菌E.肺炎球菌6.细菌的合成代谢产物是指A.热原质B.毒素C.透明质酸酶D.色素E.抗生素7.细菌的分解代谢产物是指A.细菌素B.硫化氢C.吲哚D.维生素E.外毒素8.吲哚(靛基质)试验呈阳性的细菌是A.霍乱弧菌B.伤寒杆菌C.肺炎杆菌D.变形杆菌E.大肠杆菌9.产硫化氢的致病菌是A.鼠伤寒杆菌B.大肠杆菌C.痢疾杆菌D.变形杆菌E.肺炎杆菌10.专性厌氧生长的细菌是:A.破伤风梭菌B.空肠弯曲菌C.幽门螺杆菌D.脆弱类杆菌E.葡萄球菌11.专性需氧生长的细菌是:A.结核分枝杆菌B.霍乱弧菌C.伤寒杆菌D.绿脓杆菌E.链球菌12.湿热灭菌优于干热灭菌的是A.导热快B.穿透力强C.比干热灭菌所需的温度低D.潜热E.使细菌蛋白迅速凝固变性13.多数细菌怕干燥,但有少数菌抗干燥能力较强,它们是A.脑膜炎球菌B.淋球菌C.溶血性链球菌D.结核杆菌E.炭疽芽胞杆菌14.对于病人排泄物与分泌物(如粪,尿,脓,痰)的处理,常用的消毒剂有A.20%漂白粉B.5%石炭酸C.2%来苏D.70%乙醇E.2.5%碘酒1.噬菌体的特性有A.能通过滤菌器B.没有完整的细胞结构C.只含有一种核酸D.专性活细胞寄生E.以复制方式生长繁殖3.毒性噬菌体溶菌周期的步骤有A.吸附B.穿入C.生物合成D.组装成熟E.释放1.遗传性变异中细菌基因转移与重组的方式是A.转化B.转导C.接合D.溶原性转换E.原生质2.质粒DNA的特征有A.自我复制B.赋予细菌产生新的生物学性状C.可自行丢失与消除D.能转移E.相容性与不相容性3.医学上重要的质粒有A.R质粒B. F质粒C. Col质粒D.毒力质粒E. r质粒4.能以接合方式转移的质粒是A. R质粒B. F质粒C. Col质粒D.毒力质粒E. r质粒1.属于胞内寄生的病原菌是A.结核杆菌B.伤寒杆菌C.麻风杆菌D.大肠杆菌E.肺炎杆菌2.构成细菌致病性毒力的物质是A.内毒素B.外毒素C.荚膜D.菌毛E.膜磷壁酸3.以产神经性毒素致病的细菌有A.伤寒杆菌B.破伤风梭菌C.肉毒梭菌D.霍乱弧菌E.肺炎球菌4.内毒素的毒性作用有A.发热B.血管内皮细胞受损C.DICD.白细胞反应E.微循环衰竭5.抗毒素A.可由类毒素刺激机体产生B.可由外毒素刺激机体产生C.为外毒素经甲醛处理后获得D.可中和与易感细胞结合的外毒素的毒性作用E.可中和游离外毒素的毒性作用6.构成机体非特异性免疫的因素包括A.皮肤与粘膜机械性阻挡与屏障作用B.血脑与胎盘的屏障作用C.吞噬细胞的吞噬作用D.正常体液与组织中抗菌物质的作用E.呼吸道,消化道局部粘膜中分泌型IgA的作用7.能产肠毒素的病原菌有A.肠产毒性大肠杆菌B.链球菌C.霍乱弧菌D.金黄色葡萄球菌E.伤寒杆菌8.正常菌群的有益作用是A.生物屏障作用B.抗肿瘤作用C.刺激干扰素的合成D.增强免疫细胞活性E.合成维生素1.IMViC试题主要用于鉴别A.葡萄球菌B.白喉杆菌C.产气杆菌D.大肠杆菌E.流感嗜血杆菌2.可以用抗毒素进行紧急预防和治疗的疾病有A.梅毒B.白喉C.破伤风D.伤寒E.细菌性痢疾3.属于细胞免疫制剂的是A.TFB.IFNC.IL-2K细胞E.抗菌血清1. 鉴定金黄色葡萄球菌可依据的指标有A. 金黄色色素B. 分解甘露醇C. 产生凝固酶D. 产生耐热核酸酶E. 产生溶血毒素2. 在医学上重要的化脓性球菌有A. 葡萄球菌B. 链球菌C. 肺炎球菌D. 脑膜炎球菌E. 淋球菌3. 引起性病的病原体有A. 四联球菌B. 淋球菌C. 梅毒螺旋体D.八叠球菌E. 变形杆菌4. 与脑膜炎球菌致病有关的物质是A. 芽胞B. 荚膜C. 菌毛D. 内毒素E. 鞭毛5. 金黄色葡萄球菌的致病物质有A. 杀白细胞毒素B. 溶血毒素C. 肠毒素D. 表皮剥脱毒素E. 血浆凝固酶6. 在血琼脂平板培养基上培养,可形成草绿色溶血环的细菌是A. 甲型溶血性链球菌B. 乙型溶血性链球菌C. 肺炎链球菌D. 表皮葡萄球菌E. 腐生葡萄球菌7. 常用巧克力色培养基培养的细菌是A. 白色葡萄球菌B. 肺炎链球菌C. 柠檬色葡萄球菌D. 脑膜炎球菌E. 淋球菌1. 患以下疾病后可获得持久免疫力的是A. 白喉B. 伤寒C. 细菌性痢疾D. 百日咳E. 霍乱A. 鼠伤寒杆菌B. 猪霍乱杆菌C. 肠炎杆菌D. 变形杆菌E. 肺炎杆菌3. ETEC可产生的两种肠毒素是A. LT肠毒素B. ST肠毒素C. RT肠毒素D. S肠毒素E. VT肠毒素4. 志贺外毒素,具有的生物活性有A. 细胞毒性B. 肠毒性C. 神经毒性D. 凝血性E. 溶血性5. 痢疾志贺菌的致病物质有A. 鞭毛B. 菌毛C. 透明质酸酶D. 外毒素E. 内毒素6. 致人类腹泻的细菌有A. 霍乱弧菌B. 肠产毒性大肠杆菌C. 肠侵袭性大肠杆菌D. 肠致病性大肠杆菌E. 肠出血性大肠杆菌1. 霍乱弧菌的致病物质有A. 鞭毛B. 菌毛C. 肠毒素D. 外毒素E. 透明质酸酶2. 关于副溶血性弧菌的致病性,系列哪些是正确的A. 食入未煮熟的海产品感染B. 潜伏期为72hC. 主要致病物质为耐热溶血毒素D. 主要症状为腹痛、腹泻、呕吐、发热等E. 病后免疫力不强1. 属于专性厌氧菌的是A. 破伤风梭菌B. 肉毒梭菌C. 脆弱类杆菌D. 消化性链球菌E. 炭疽杆菌2. 主要以外毒素致病的细菌是A. 产气荚膜梭菌B. 破伤风梭菌C. 肉毒梭菌D. 脑膜炎双球菌E. 痢疾杆菌3. 产气荚膜梭菌引起人类疾病的类型有A. 慢性脑膜炎B. 气性坏疽C. 食物中毒D. 坏死性肠炎E. 蜂窝组织炎A. 鼠伤寒沙门菌B. 产气荚膜梭菌C. 肉毒梭菌D. 金黄色葡萄球菌E. 副溶血性弧菌1. 具有致病性的主要放线菌是A. 衣氏放线菌B. 黏液放线菌C. 龋齿放线菌D. 牛放线菌E. 内衣放线菌2. 能引起人类疾病的诺卡菌有A. 星形诺卡菌B. 豚鼠诺卡菌C. 巴西诺卡菌D. 内衣放线菌E. 黏液放线菌3. 衣氏放线菌的特点有A.抗酸染色阳性B. 在病灶组织中形成"硫磺样颗粒"C.在感染部位常形成瘘管D.口腔中正常菌群E. 厌氧培养1.具有异染颗粒的细菌是A. 白喉棒状杆菌B. 鼠疫杆菌C. 葡萄球菌D. 肺炎球菌E. 结核杆菌2.人工培养白喉棒状杆菌所用的培养基有A. 吕氏血清斜面培养基B. 血平板培养基C. EMB培养基D. 亚碲酸钾培养基E. SS培养基1. 下列细菌中属于胞内寄生菌的有A. 结核分枝杆菌B. 麻风分枝杆菌C. 伤寒杆菌D. 肺炎杆菌E. 大肠杆菌2. 结核分枝杆菌侵入机体的途径有A. 呼吸道B. 消化道C. 破损皮肤D. 节肢动物叮咬E. 直接接触3.结核菌素试验称阳性反应,表明机体A. 已感染过结核分枝杆菌B. 接种卡介苗成功C. 对结核分枝杆菌有迟发型超敏反应D. 对结核分枝杆菌发生Ⅲ型超敏反应E. 对结核分枝杆菌有一定的特异免疫力4. 结核菌素试验的意义是A. 确定预防接种卡介苗的对象B. 判断卡介苗接种后的免疫效果C. 作为婴幼儿结核病的辅助诊断D. 测定肿瘤患者的细胞免疫功能E. 了解在未接种卡介苗的人群中感染结核病的流行病学调查1. 炭疽杆菌的致病物质是A. 荚膜B. 炭疽毒素C. 鞭毛D. 菌毛E. 透明质酸酶2. 布鲁氏杆菌的致病物质是A. 内毒素B. 荚膜C. 透明质酸酶D. 过氧化氢酶E. 胶原酶3. 鼠疫杆菌的致病物质有A. FI抗原B. V-W抗原C. MT抗原D. 保护性抗原E. 水肿因子4. 鼠疫杆菌产生的鼠毒素特点有A. 内毒素B. 化学成分是蛋白质C. 外毒素D. 细菌死亡裂解后释放E. 可以脱毒成类毒素5. 炭疽杆菌的生物学特点有A. 芽胞B. 荚膜C. 鞭毛D. 革兰阳性粗大杆菌E. 专性厌氧6. 经鼠类传播的病原微生物有A. 鼠疫杆菌B. 钩端螺旋体C. 肾综合征出血热病毒D. 莫氏立克次体E. 普氏立克次体1. 与性传播疾病相关的细菌是A. 淋球菌B. 杜克嗜血杆菌C. 耻垢杆菌D. 结核分枝杆菌E. 布氏杆菌2. 以下哪些细菌感染后,机体的特异性免疫属于有菌免疫A. 结核杆菌B. 伤寒杆菌C. 布氏杆菌D. 痢疾杆菌E. 霍乱弧菌3. 可引起脑膜炎的细菌有A. 流感嗜血杆菌B. 脑膜炎球菌C. 结核杆菌D. B群链球菌E. 痢疾志贺菌4. 铜绿假单胞菌的致病物质包括A. 内毒素B. 菌毛C. 荚膜D. 碱性蛋白酶E. 杀白细胞素5. 流感嗜血杆菌的支部物质包括A. 荚膜B. 菌毛C. 内毒素D. 鞭毛E. 外毒素1. 性接触传播的支原体有A. 溶脲脲原体B. 人型支原体C. 生殖器支原体D. 肺炎支原体E. 穿透支原体2. 关于支原体的生物学性状,下列哪些是正确的A. 无细胞壁B. 多形态性C. 能通过滤菌器D. 细胞膜中胆固醇含量高E. 人工培养基上能生长繁殖3. 支原体与细菌的相同点是A. 有细胞壁B. 含有核糖体C. 含有两种核酸D. 能在人工培养基上生长E. 细胞核无核膜及核仁,仅有核质1. 立克次体的共同特点是A. 专性细胞内寄生,二分裂法繁殖B. 有DNA和RNA两类核酸C. 形态呈多型性,对多种抗生素敏感D. 与节肢动物关系密切E. 大多数是人兽共患病的病原体2. 斑疹伤寒立克次体的传播媒介有A. 虱B. 螨C. 蚤D. 蜱E. 白蛉3. 由节肢动物作为传播媒介所致疾病有A. 斑疹伤寒B. 伤寒C. 鼠疫D. 恙虫病E. 霍乱1. 衣原体的共同特征是A. 革兰阴性B. 具有细胞壁,对多种抗生素敏感C. 有独特发育周期D. 有核糖体和较复杂的酶系统E. 含有DNA和RNA两类核酸2. 衣原体感染的传播方式有A. 经粪-口途径传播B. 经直接接触传播C. 经性接触传播D. 经垂直传播E. 经呼吸道传播1. 钩端螺旋体的致病物质有A. 内毒素样物质B. 细胞毒因子C. 鞭毛D. 溶血素E. 荚膜2. 属于疏螺旋体属的螺旋体是A. 奋森螺旋体B. 回归热螺旋体C. 伯氏螺旋体D. 梅毒螺旋体E. 雅司螺旋体3. 可引起人畜共患病的螺旋体是A. 钩端螺旋体B. 回归热螺旋体C. 梅毒螺旋体D. 奋森螺旋体E. 伯氏疏螺旋体1,新型隐球菌致病性的特点是A,新型隐球菌引起的感染大多为外源性感染 B,主要经过呼吸道感染C,致病物质主要是荚膜 D,易引起肺部感染E,易侵犯中枢神经系统引起慢性脑膜炎2,下列为条件致病性真菌的是A,白色念珠菌 B,曲霉菌 C,毛霉菌 D,卡氏肺孢菌 E,酵母菌1.病毒的复制周期包括A.吸附B.穿入C.脱壳D.生物合成E.释放2.病毒基因组在细胞核内复制的有A.疱疹病毒B.痘类病毒C.腺病毒D.VZV病毒E.流感病毒1.可引起垂直传播的病毒有A.HIVB.风疹病毒C.HBVD.HCMVE.HSV2.构成病毒持续感染的机制可能是A.病毒抗原性变异B.病毒基因整合C.DIP形成D.机体免疫功能低下E.遗传因素3.与肿瘤发生密切相关的病毒有A.EBVB.HPV16C.HBVD.HEVE.HTLV-11.减毒活疫苗对人体有潜在危险性的原因可能是A.回复性变异B.激活机体潜伏病毒C.可引起持续感染D.不便于保藏E.可能进入机体非寻常部位,引发相应并发症2.获得主动免疫的途径有A.疫苗接种B.哺乳C.隐形感染D.显性感染E.注射干扰素1.通过病毒血症引发全身性感染的呼吸道病毒由A.流感病毒B.麻疹病毒C.腮腺炎病毒D.柯萨奇病毒E.风疹病毒2.甲型流感病毒易发生变异的原因是A.病毒核酸DNA分节段B.病毒基因组易发生重组C.核蛋白易发生变异D.HA与NA易发生变异E.病毒核酸为一ssRNA,且分节段,易发生基因重组3.可引起中枢神经系统感染的有A.流感病毒B.风疹病毒C.麻疹病毒D.呼吸道合胞病毒E.副流感病毒1.脊髓灰质炎病毒的致病特点包括A.主要通过粪-口传播B.多为隐形感染C.可形成两次病毒血症D.可引起肢体迟缓性麻痹E.极少发展为延髓麻痹2.诊断肠道病毒感染的标本可选用A.粪便B.血液C.脑脊液D.心包液E.鼻咽拭子3.柯萨奇病毒可致的人类疾病有A.无菌性脑膜炎B.心肌炎C.胸痛D.手足口病E.疱疹行咽炎1.可引起无菌性脑膜炎的病原体是A.柯萨奇病毒B.埃可病毒C.结核杆菌D.脑膜炎双球菌E.大肠杆菌2.核酸分节段的病毒是A.流感病毒B.轮状病毒C.甲肝病毒D.埃可病毒E.柯萨奇病毒3.引起人类急性胃肠炎的病毒是A.轮状病毒B.星状病毒C.杯状病毒D.Norwalk病毒E.肠道腺病毒40,41,42型4.可引起中枢神经系统感染的肠道病毒是A.麻疹病毒B.风疹病毒C.流行性乙型脑炎病毒D.埃可病毒E.柯萨奇病毒1,HBV基因组负链上含有A.S基因B.X基因C.P基因D.C基因E.pre-S1基因2,丁型肝炎病毒的描述中错误的是A.核酸类型为闭合环状RNAB.病毒颗粒外壳由HDAg组成C.可构成HBV联合感染D.乙肝疫苗不能预防丁肝病毒的感染E.检查主要以粪便中查出抗-HDIgM抗体为指标3,关于HCV的描述正确的是A.核酸类型为-ssRNAB.脂溶剂可去除病毒颗粒的感染性C.主要分6各基因型,其中我国以Ⅱ型为主D.致病可有肝外症状E.HBV常协同感染4,可通过性接触传播的是A.HAVB.HBVC.RSVD.HCMVE.HSV1,黄热病毒的共同特征为A,病毒基因组为单正链RNA B,病毒均在细胞质内增殖C,人,家畜等受蚊,蜱等节肢动物叮咬后获得感染D,病毒对脂溶剂不敏感 E,感染后多出现两次病毒血症2,乙型脑炎的预防措施包括A,预蚊和灭蚊 B,婴幼儿接种疫苗 C,幼猪接种疫苗 D,灭蜱及防蜱叮咬 E,灭鼠1,肾综合征出血热病毒感染引起的典型临床表现有A,高热 B,出血和肾损害C,头痛,眼眶痛,腰痛 D,口颊部Koplik斑E,面,颈,上胸部潮红2,对肾综合征出血热病毒易感的动物有A,黑线姬鼠 B,长爪沙鼠 C,大鼠 D,乳小鼠 E,金地鼠1,与致癌有关的有A,HCMV B,EBV C,HSV-2 D,HPV-16 E,HBV2,HCMV常潜伏的部位为A,唾液腺 B,肾 C,单核细胞 D,乳腺 E,巨噬细胞3,疱疹病毒可引起A,先天性感染 B,隐性感染 C,慢发感染D,潜伏感染 E,显性感染1,HIV致病机制包括A,病毒基因组整合感染 B,诱导自身免疫病 C,选择性损伤CD4+细胞D,宿主细胞膜上表达的HIV糖蛋白引发免疫攻击E,受染细胞与邻近细胞融合,导致细胞死亡2,HIV感染的临床主要特点是A,潜伏期较长 B,并发肿瘤 C,病毒可侵犯多器官及脏器 D,免疫系统严重受损E,合并各种机会感染1,可侵犯中枢神经系统的是A,狂犬病毒 B,腮腺炎病毒 C,HIV D,柯萨奇病毒 E,B192目前已知朊粒能引起人与动物的疾病有A,库鲁病 B,羊骚痒病 C,克雅病 D,牛海绵脑病 E,致死性家族失眠症。

原核微生物(prokaryotic microbe):指核质和细胞质之间不存在明显核膜,其染色体由单一核酸组成的一类微生物。
原核细胞型微生物(procaryotic cell microbe):指没有真正细胞核(即核质和细胞质之间没有明显核膜)的细胞型微生物。
真核细胞型微生物(eukaryotic cell microbe):指具有真正细胞核(即核质和细胞质之间存在明显核膜)的细胞型微生物。
真菌(fungi):有真正细胞核,没有叶绿素的生物,它们一般都能进行有性和无性繁殖,能产生孢子,它们的营养体通常是丝状的且有分枝结构,具有甲壳质和纤维质的细胞壁,并且常常是进行吸收营养的生物。
霉菌(Mold):具有丝状结构特征的真菌。
细菌(bacterium):单或多细胞的微小原核生物。
病毒(virus):是一类没有细胞结构但有遗传复制等生命特征,主要由核酸和蛋白质组成的大分子生物。
是比细菌更小的专性细胞内寄生的微生物,大多数能通过细菌过滤器。
放线菌(actionomycetes):一目形成真的菌丝成分枝丝状体的细菌。
蓝细菌(cyanobacterium):是光合微生物,蓝细菌是能进行光合作用的原核微生物。
原生生物(protistan):指比较简单的具有真核的生物。
原生动物(protozoa):单细胞的原生生物。
免疫学(immunology):研究利用预防接种法治疗疾病的科学。
立克次氏体(Richettsia):节肢动物专性细胞内寄生物,它的许多类型对人和其它动物是致病的微生物。
感染(Infection):宿主由于微生物生长的病理学状况。
巴氏灭菌法(pasteurization):亦称低温消毒法,冷杀菌法,利用较低的温度既可杀死病菌又能保持物品中营养物质风味不变的消毒法。
巴斯德消毒法(Pasteurization):在一控制温度给液体食物或饮料加热以提高保藏质量,同时也消毀有害的微生物。
化学疗法(chemotherapy):用化学药物来治疗传染病。

原核细胞型微生物原核细胞型微生物是指一类没有细胞核和其他细胞器的微生物,其细胞直径通常在1至10微米之间,主要包括细菌、蓝藻和古菌等。
这种微生物具有很强的繁殖能力,可以从简单的有机物和无机盐中获得所需的营养,在生态系统中起着重要的作用。
1. 细菌细菌是广泛存在于自然界中的微生物,其形态多样,有球形、杆状、螺旋形等。
在细菌中,有些能够进行光合作用,有些则不能,比如大肠杆菌和沙门氏菌等。
细菌中的类群包括革兰氏阳性菌和革兰氏阴性菌,后者的细胞壁比较复杂,具有内外两层壳,并且在细菌中还有许多致病菌,比如黄热病、霍乱和肺炎等。
2. 古菌古菌生活在高温、高压和强酸等极端环境中,常见的有嗜热古菌和嗜酸古菌。
其细胞壁由甘露聚糖、蛋白质和聚糖等构成,比较坚韧,可以承受极端条件。
古菌可以利用氢气、甲烷或硫化氢等化合物进行生存,其代谢途径和基因表达方式与其他微生物有很大不同。
3. 蓝藻蓝藻是一类自养细菌,可以进行光合作用,具有与植物类似的叶绿素和类胡萝卜素。
蓝藻在自然界中普遍存在于水生环境和土壤中,包括单细胞和多细胞形式,有些多细胞蓝藻会形成菜农和珊瑚礁等生态系统。
4. 放线菌放线菌是属于细菌界的一类微生物,外形是类似长棍状的,能够在土壤、水、海沟等复杂的生态环境中生存。
放线菌可以产生多种抗生素,包括链霉素、青霉素和四环素等,这些抗生素在医药、食品和饲料加工等行业中有广泛的应用。
5. 蓝细菌蓝细菌也是一类进行光合作用的微生物,生活在水体中,有些蓝细菌还可以产生氮,对植物生长有帮助。
蓝细菌中的代表物种包括德氏蓝菌和赤藻等,这些生物在太阳能、碳循环和生态系统稳定性等方面发挥着重要作用。
总之,原核细胞型微生物具有很高的生存适应性和环境承受力,可以通过各种代谢途径获得所需的营养和能量,对生态系统和人类生活产生着重要的影响。
随着生物技术和研究手段的不断发展,人们对于原核细胞型微生物的研究也将日益深入。
临床执业医师分类模拟题24含答案临床执业医师分类模拟题241. 下列不属于原核细胞型微生物的是A.细菌B.支原体C.衣原体D.真菌E.立克次体答案:D[解答] 原核细胞型微生物包括细菌、支原体、衣原体、立克次体、螺旋体和放线菌等,而真菌属于真核细胞型微生物。
2. 下列属于原核细胞型微生物的是A.隐球菌、结核分枝杆菌B.放线菌、破伤风梭菌C.链球菌、念珠菌D.酵母菌、淋球菌E.小孢子菌、大肠埃希菌答案:B[解答] 酵母菌、念珠菌、隐球菌、小孢子菌均属于真核细胞型微生物。
A.真菌B.病毒C.支原体D.螺旋体E.衣原体3. 上述各项中只有一种核酸类型的微生物是答案:B[解答] 病毒是最微小的结构最简单的一类非细胞型微生物,它只含有一种类型的核酸。
是由一个核酸分子(DNA或RNA)与蛋白质构成的非细胞形态的营寄生生活的生命体。
4. 上述各项中缺乏细胞壁的原核细胞型微生物是答案:C[解答] 支原体没有细胞壁,呈高度多形态性,能通过滤器,是可用于人工培养基培养增殖的一类最小的原核细胞型微生物。
5. 有完整细胞核的微生物是A.立克次体B.放线菌C.细菌D.真菌E.衣原体答案:D6. 下列哪项是细菌细胞壁特有的成分A.肽聚糖B.类脂AC.脂蛋白D.脂多糖E.外膜答案:A7. 关于细菌芽孢最显著的特性描述正确的是A.抗吞噬性B.侵袭性C.耐热性D.粘附性E.具有毒素活性答案:CA.中介体B.包涵体C.吞噬体D.线粒体E.异染颗粒8. 上述各项中与细菌的呼吸作用有关的结构是答案:A9. 上述各项中可用于鉴别细菌的结构是答案:E10. 在病毒的增殖过程中,可出现上述哪种结构答案:B11. 关于溶菌酶的溶菌作用机制描述正确的是A.裂解细胞壁聚糖骨架上的β-1,4糖苷键B.抑制细胞壁肽聚糖上四肽侧链与五肽桥的交联C.抑制细菌mRNA表达D.破坏细胞壁上的磷壁酸E.抑制细菌DNA转录答案:A12. 与细菌耐药性有关的结构是下列哪项A.性菌毛B.质粒C.鞭毛D.细菌染色体E.异染颗粒答案:B13. 细菌个体的繁殖方式属于A.核酸复制B.菌丝断裂C.细胞出芽D.无性二分裂E.有性繁殖答案:D14. 在流行病学调查中,可用于细菌分型的合成性代谢物是下列哪项A.色素B.酶类C.毒素D.热原质E.细菌素15. 在1.05kg/cm2蒸气压力下,灭菌的标准时间为A.1~5分钟B.6~10分钟C.11~14分钟D.15~20分钟E.21~25分钟答案:D[解答] 高压蒸汽灭菌法是在1.05kg/cm2蒸汽压下,温度达到121.3℃,维持15~20min,可杀灭包括细菌芽孢在内的所有微生物。
原核细胞型微生物名词解释
原核细胞型微生物是生物分类中的一种类型,具有极高的适应性和巨大的生物量,对地球生命环境以及生物群落的影响十分显著。
由于其细胞结构相对简单,不包含有真核的膜结构,因此被命名为"原核细胞"。
原核细胞型微生物分为两大类:细菌和古菌。
细菌遍布在陆地、海洋、淡水,甚至极端环境,如热泉、盐湖等。
它们可以是自养的、异养的、光合作用或者化学合成。
细菌的形状和大小各异,展现了多种多样的形态。
有益的细菌在食品工业、农业、医药等许多领域具有广泛的应用。
另一类原核细胞型微生物是古菌,古菌是一类在极端环境中生活的微生物,如高温、高盐、低氧等。
它们具有一定的抗压性和耐受性,结构和功能明显区别于
细菌和真核生物。
据研究发现,古菌具有特异的培养需求和生长环境,推测其可能是地球上最早的生命形式之一。
尽管原核细胞型微生物的类型丰富多样,但其共同点是内含的遗传物质(DNA)均分布在胞浆中,无膜结构将其包裹。
其中又以质膜、染色体、细胞壁和鞭毛等结构为典型。
此外,许多原核细胞型微生物还拥有荚膜和类胞鞭毛等外在附加机构,以帮助其在环境中生存。
原核细胞型微生物的繁殖方式通常是二分裂,即通过DNA的复制和细胞的分
裂来进行。
部分原核细胞型微生物也可通过突变或者遗传重组实现变异,以适应
环境的改变。
原核微生物在生物学研究、环境改善、医疗保健、生物工程等各个领域起到了重要作用。
尽管部分原核微生物可能会导致人类或动物的疾病,但大部分原核微生物对生命活动的维持和推动起到了积极的作用。
第一节细菌一形态(一) 形状:基本形状球状----球菌杆状---杆菌螺旋状----螺旋菌1.球菌基本形状:圆球形、扁圆球形、椭圆球形种类(依子细胞的空间排列方式分):单球菌一个方向分裂子细胞分散双球菌一个方向分裂子细胞成对排列链球菌一个方向分裂子细胞链状排列四联球菌二个方向分裂,子细胞田字形排列八叠球菌三个方向分裂,子细胞立方形排列葡萄球菌多个方向分裂,子细胞葡萄状排列2.杆菌基本形状杆状圆柱状同一种杆菌宽度比较稳定,长度易变种类与工农业生产关系密切大多数杆菌菌体分散存在,如鼠疫巴氏杆菌、大肠杆菌、麻风杆菌、痢疾志贺氏菌有些呈链状排列、栅状排列、八字形排列,如苏云金杆菌。
3.螺旋菌基本形状弯曲杆状包括o弧菌菌体弯曲呈弧形或逗号形,如霍乱弧菌o螺旋菌菌体回转如螺旋状,如红螺菌(二)大小单位微米1mm=1000μm球菌大小以直径表示:0.5-2.0微米杆菌宽度与球菌相似,长度:0.2-8.0微米螺旋菌大小以菌体两端点间距离表示(三)影响细菌形状和大小的因素菌龄环境条件o环境条件适宜的幼龄菌,表现正常的大小和形态o环境温度偏高、营养条件失调的老龄菌,菌体萎缩二、细菌的细胞结构所有的细菌都有共同的基本结构细胞壁o原生质体(细胞膜、细胞质、原核)某些细菌有特殊结构o如鞭毛、荚膜、芽孢等(一)基本结构1.细胞壁·功能a)维持细胞外形b)保护原生质体,在渗透压不宜的环境中保持生命力Gram staining1884年丹麦医生C.Gram涂片→结晶紫初染(紫色)→碘液处理→乙醇脱色→复红复染(红色) 除支原体、螺旋体、细菌L型外,所有原核生物均有细胞壁,可区分为Gram阳性或阴性菌,两者在化学组成及细胞壁结构上差异显著可能原理结晶紫-碘复合物o阳性菌壁厚,肽聚糖含量高,结构紧密,含脂量少;酒精脱色,肽聚糖不溶于酒精,紫色不褪,复染不能进行o阴性菌相反肽聚糖是原核生物细胞壁特有的化学组成,青霉素等能破坏其结构或抑制其合成2.细胞膜(细胞质膜)功能a)物质转运与营养作用,渗透屏障b)呼吸作用与生物合成作用中心化学组成蛋白质 60-70% 磷脂 20-30% 多糖 2%3.细胞质:细胞膜内、除细胞核外的细胞物质形状a)无色、透明、粘稠、胶状成分b)水、蛋白质、核酸、脂类等构成c)核糖体、载色体、颗粒状内含物、气泡等4.细胞核没有核膜,称拟核、染色质体功能o贮存遗传信息很多细菌带有质粒o环状DNA分子,可复制、转移(二)某些细菌的特殊结构1.鞭毛a)部分细菌菌体表面产生的细长、波浪形丝状物A.有鞭毛的细菌种类大多数球菌无鞭毛o部分杆菌有鞭毛o所有孤菌,螺旋菌均有鞭毛o一些真核生物亦有鞭毛B.鞭毛着生位置依鞭毛着生位置侧生鞭毛菌周生鞭毛菌端生鞭毛菌C.结构D.功能与细菌运动有关o运动机制未详除具鞭毛的细菌能运动外o粘细菌、蓝细菌能滑行运动、但限于固体培养基上o螺旋体借助轴丝运动2.荚膜细菌细胞壁表面覆盖的一层松散的粘液性物质o具一定外形,相对稳定地附于细胞壁---- 荚膜o没有明显边缘,可扩散到周围环境---- 粘液层菌胶团:多个菌体共一个荚膜A.荚膜对细菌菌落的影响S型菌落:能产生荚膜细菌,表面光滑(smoth)R型菌落:不能产生荚膜细菌,表面干燥,粗糙(Rough)B.功能保护菌体o免受干燥体外贮藏营养物质3.芽孢某些细菌到了一定的生长发育阶段,在营养细胞内形成对不良环境条件具较强抵抗力的内生孢子(休眠体)形状:o圆形,椭圆形,圆柱形表面形状能形成芽孢的细菌球菌o生孢八叠球菌属杆菌o好气性芽孢杆菌属o厌气性梭状芽孢杆菌属能否形成芽孢是种的特征,与环境条件无关o能形成:到一定生长阶段即形成o不能形成:条件再恶劣都不能形成结构孢外壁:含耐热物质DPA(吡啶2.6一二羧酸)芽孢衣皮层核心形成:营养细胞部分原生质浓缩失水而成作用抵抗不良环境o抗热: 营养细胞 100℃ 10分芽孢 121℃ 20—30分o抗干燥o抗药性保存生命力:遇适宜环境,吸水膨胀,发芽生长三、细菌繁殖与群体结构1.繁殖裂殖:无性繁殖,进行细胞横分裂速度o 20—30分/代o比植物快500倍,比动物快2000倍o条件适宜,1个细胞 4万亿亿(24hours)2. 群体结构菌落(colony) :固体培养基上,局限在一处大量繁殖,形成肉眼可见的群落菌苔:斜面或平面培养基表面形成的连片培养物菌膜、菌环等3. 菌落描述大小、形状隆起形状、边缘情况表面状态、表面光泽质地、颜色透明程度如黄单胞杆菌菌落描述为:较大,圆形,高凸起,边缘整齐表面光滑,表面金色光泽粘,黄色不透明第二节放线菌(Actinomycetes)特点大多数为Gram阳性菌具有发育程度不同的分枝丝状体产生分生孢子或孢囊孢子等无性孢子进行繁殖产生抗菌素(链霉素、庆大霉素、春雷霉素、土霉素、四环素、氯霉素、红霉素等)一.分布腐生分布区域o土壤为主o空气、淡水、海水为辅在含水量较少,富含有机质的中性或偏碱性土壤中分布最多二.形态结构o单细胞o原核不断复制,细胞不分裂,菌丝无隔膜o菌丝直径0.5-1mm,长度和分枝无限制结构完整o壁、膜、质、原核构成菌丝种类依形态和功能分:营养菌丝又称:基内菌丝,一级菌丝位置:伸入培养基内,可产生色素功能:吸收营养物质、水分气生菌丝又称:二级菌丝位置:生长在培养基表面向空间伸展功能:繁殖,输送养分、水分孢子丝位置:由部分气生菌丝生长发育到一定阶段分化形成,可产生孢子功能:繁殖、孢子着生形状:直形、波浪、轮生、螺旋状三.放线菌繁殖与菌落特征1.繁殖菌丝片段(诺卡氏属放线菌)无性孢子o分生孢子o裂殖方式形成(链霉菌属)o孢囊孢子o菌丝顶端形成孢子囊,内有孢囊孢子(游动放线菌科)2.菌落特征菌丝组成质地致密,表面干燥,多皱与培养基结合紧密,不易挑起四、代表属原核生物界、放线菌目、14科、56属与食品工业关系密切的有:链霉菌属(Streptomyces)、诺卡氏菌属(Nocardia)第三节.蓝细菌(cyanobacteria)——又称蓝绿藻、蓝藻1分布:水域(池塘、湖泊、海洋)、土壤、岩石、树皮等2 形状单细胞直径或宽度3~10um3 结构中心:核区周围o细胞质o含色素、叶绿素a 、藻胆蛋白(藻蓝素、异藻蓝素、藻红素)4 特点进行光合作用:放氧、光能自养分布广泛、生活力强部分能固氮代表属:微囊藻属(Microeystis)、鱼腥藻属(Anabaena):红萍鱼腥藻第四节、立克次氏体(Rickettsia)纪念H.Ricketts :1909年研究斑疹伤寒感染而去世症状:头痛→寒战、高烧→皮疹→心力衰竭死亡(12~17日)1 形状结构球形: 0.2~0.5um杆状:0.3~0.5×0.3~2um细胞结构完整2 特点Gram阴性菌专性细胞内寄生,离开寄主不能生存通过节肢动物在宿主中传播:如虱(shi)蚤(zao)蜱(pi)螨不引起节肢动物致病,叮咬传播给人类等。
绪论
一、选择题
1.下列哪一种微生物不属于原核细胞型微生物
A. 细菌
B.支原体
C. 噬菌体
D. 立克次体
E.螺旋体
2.下列哪一种微生物属于真核细胞型微生物
A.放线菌B.结核杆菌C.噬菌体D.白假丝酵母菌E.衣原体
二、填空题
1.根据形态结构和化学组成的不同微生物,可分为,和三大类。
2.原核细胞型微生物包括、、、、和。
3. 真核细胞型微生物的特点是和。
参考答案
一、选择题
1.C
2.D
二、填空题
1.非细胞型微生物、原核细胞型微生物、真核细胞型微生物
2. 细菌、衣原体、支原体、螺旋体、立克次体、放线菌
3. 细胞核分化程度高、细胞器完善。